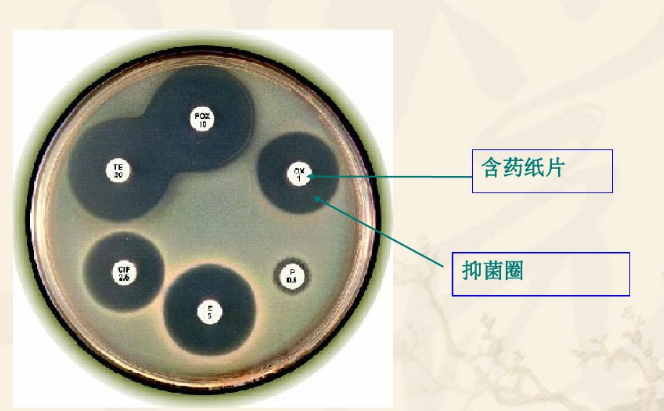

实验结果观察与分析
上一节
下一节
五 结果与讨论
1、实验结果
绘图表示并说明氨苄西林对三种微生物抑菌效能;解释其原理。以+、—表示抗生素的抑菌性能。
表1 抗生素(青霉素)对微生物的影响
| 抗生素 | |
| 金黄色葡萄球菌 | |
| 大肠杆菌 | |
| 枯草芽孢杆菌 |
测量每个平板上不同化学消毒剂抑菌圈直径,结果填于表内。
表2 化学消毒剂对微生物的影响
| 化学消毒剂 | 抑菌圈直径/mm | |
| 24小时 | 48小时 | |
| 1. 龙胆紫 | ||
| 2. | ||
| 3. | ||
| 4. | ||
| 5. | ||
| 6. | ||
| 7. | ||
| 8. | ||
注意:
抑菌圈的直径(包含纸片的直径),以毫米数报告(取整数)。根据CLSI判定标准测量抑菌圈直径大小可以判断细菌对该抗生素是敏感、中介还是耐药,如下图。

2. 结果分析与实验结论
六、思考题
(1)圆纸片抗菌试验操作时应注意什么事项?
(2)如果抑菌带内隔一段时间又长出少数菌落,你如何解释这种现象?

